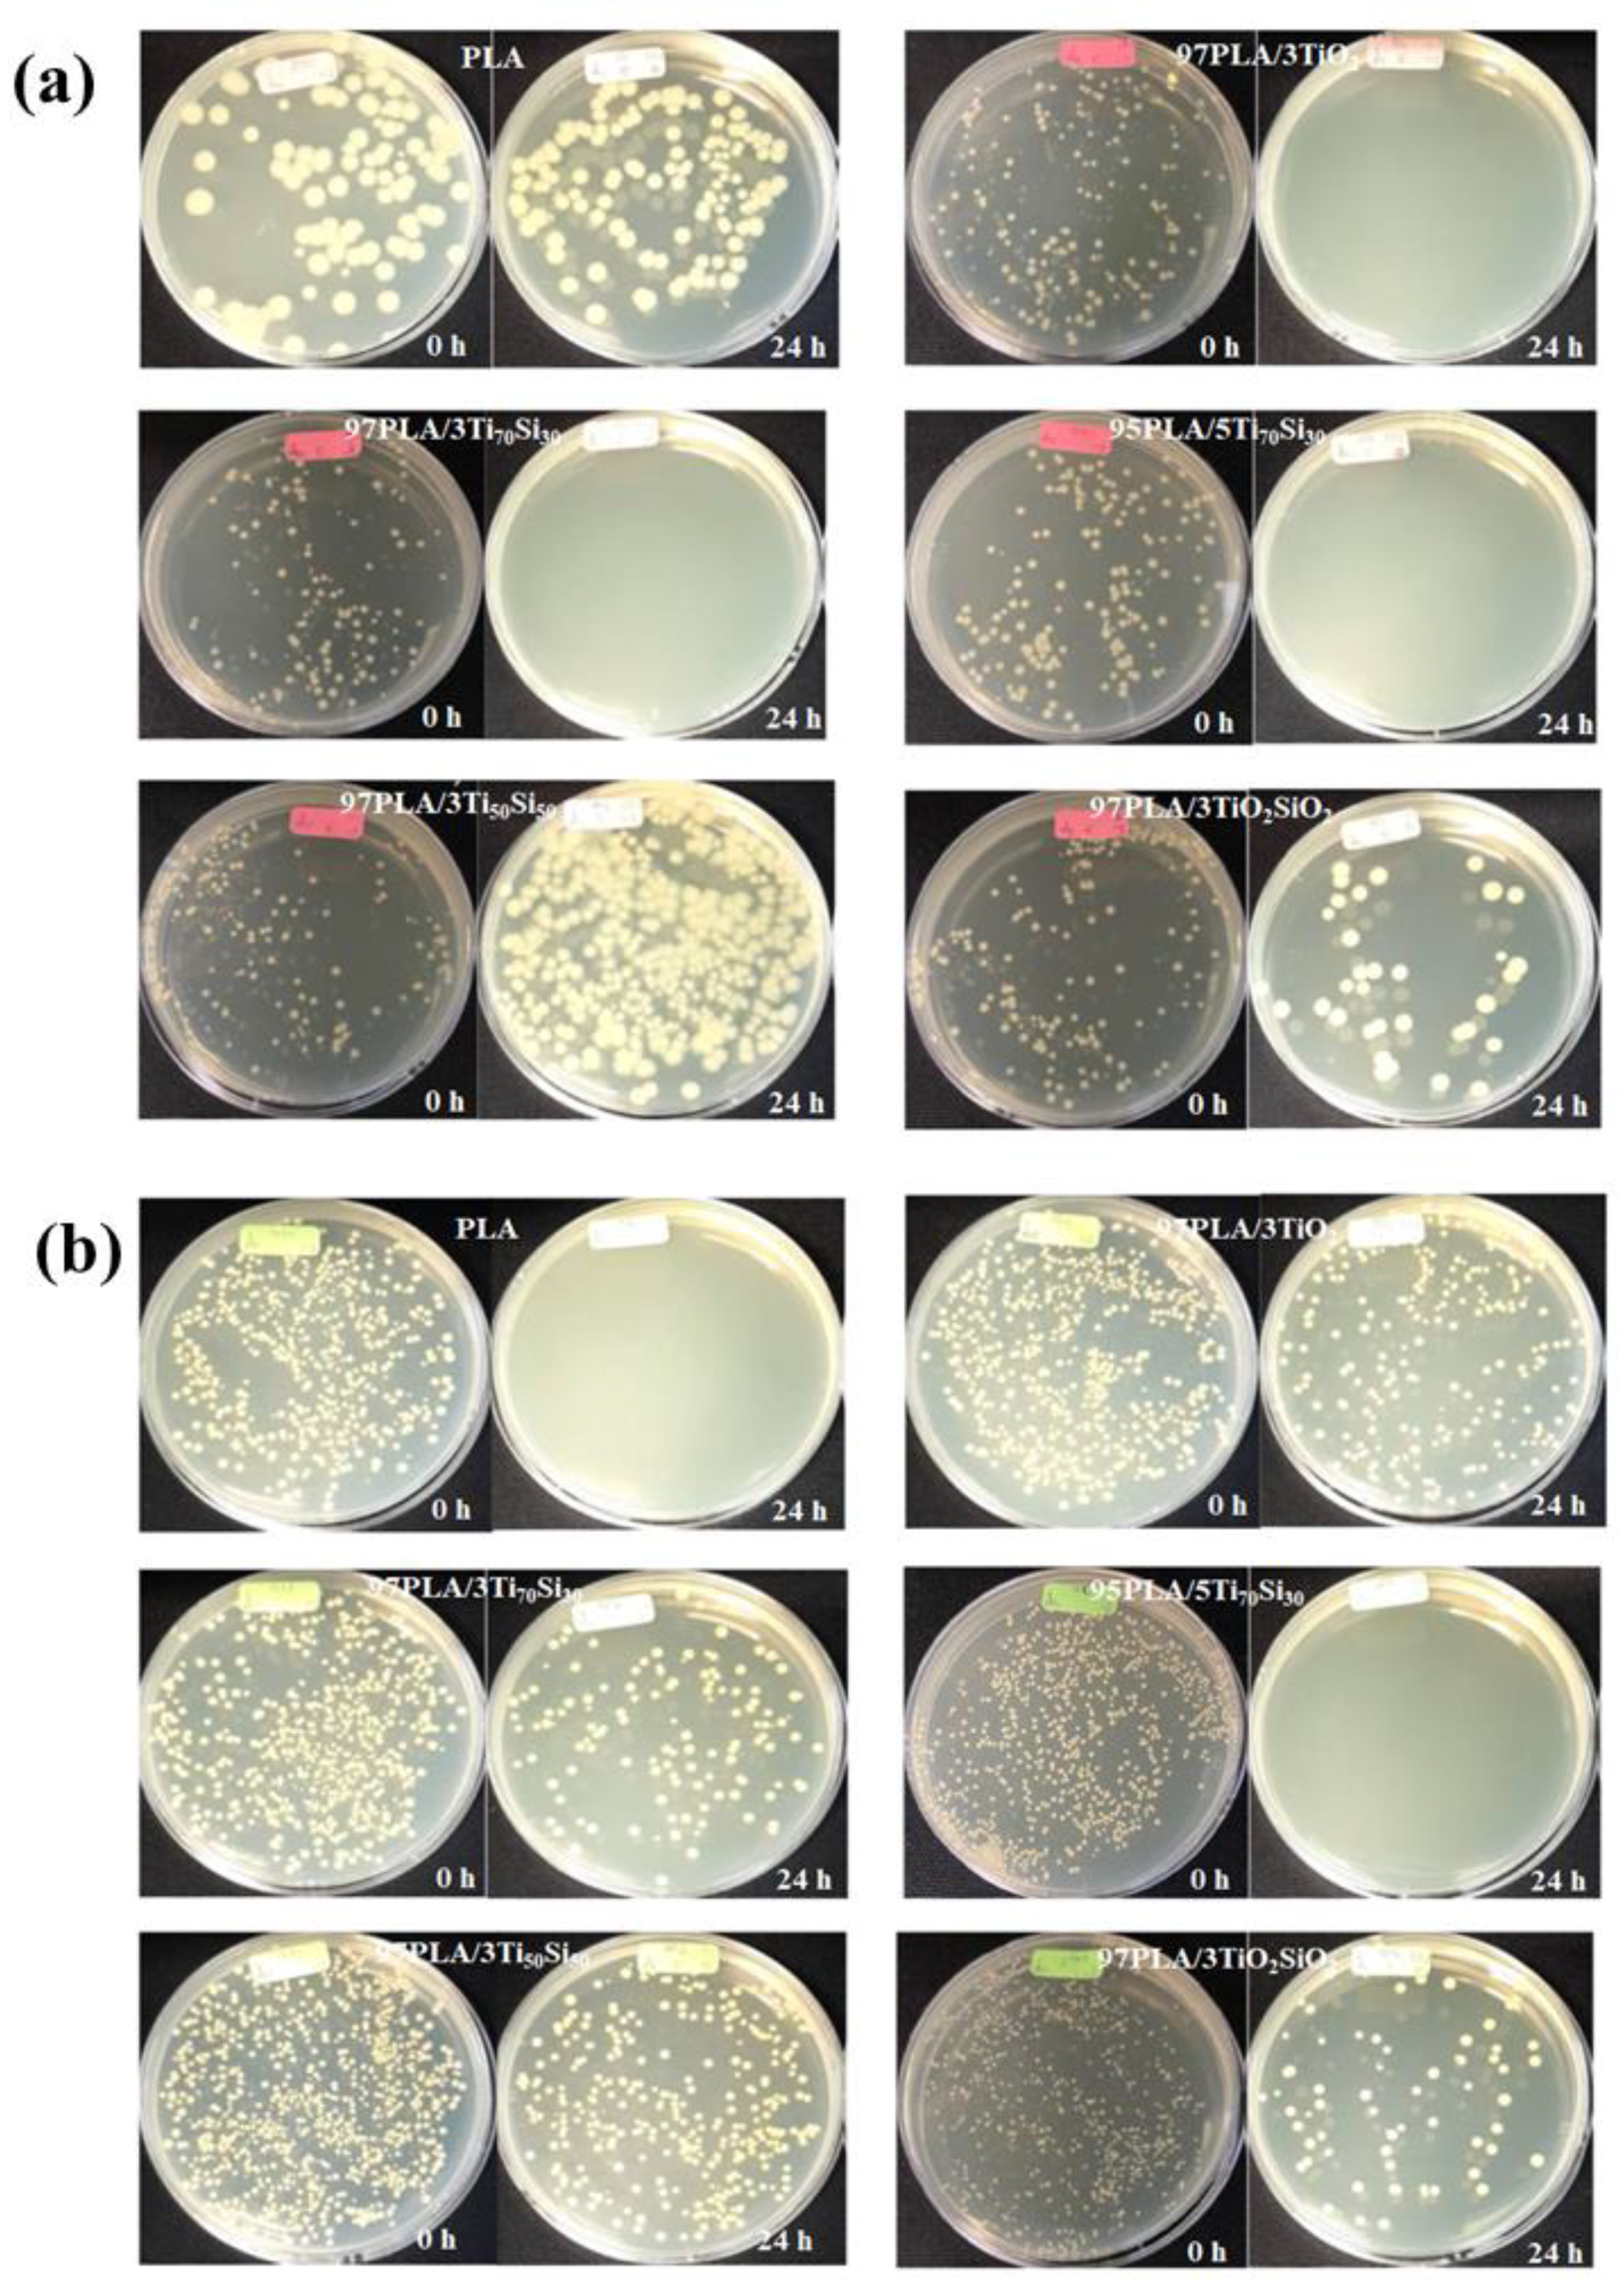
Polymers 14 03310 g012 550

Effects of Titanium–Silica Oxide on Degradation Behavior and Antimicrobial Activity of Poly (Lactic Acid) Composites
Abstract
:1. Introduction
2. Materials and Methods
2.1. Materials
2.2. Preparation of PLA Composite Films
2.3. Mechanical Properties
2.4. Thermal Properties
2.5. Morphological Properties
2.6. Water Vapor Transmission Rate (WVTR)
2.7. Photocatalytic Degradation of Methylene Blue (MB)
2.8. Light Transmittance and Opacity Measurements
2.9. Hydrolytic Degradation
2.10. In Vitro Degradation
2.11. Antimicrobial Activity
3. Results and Discussion
3.1. Mechanical Properties
3.2. Thermal Properties
3.3. Morphological Properties
3.4. Water Vapor Transmission Rate (WVTR)
3.5. Photocatalytic Degradation of Methylene Blue (MB)
3.6. Light Transmittance and Opacity Measurements
3.7. Hydrolytic Degradation
3.8. In Vitro Degradation
3.9. Antimicrobial Activity
4. Conclusions
Supplementary Materials
Author Contributions
Funding
Institutional Review Board Statement
Informed Consent Statement
Data Availability Statement
Acknowledgments
Conflicts of Interest
References
- Cadar, O.; Paul, M.; Roman, C.; Miclean, M.; Majdik, C. Biodegradation behaviour of poly(lactic acid) and (lactic acid-ethylene glycol-malonic or succinic acid) copolymers under controlled composting conditions in a laboratory test system. Polym. Degrad. Stab. 2012, 97, 354–357. [Google Scholar] [CrossRef]
- Lim, L.T.; Auras, R.; Rubino, M. Processing technologies for poly(lactic acid). Prog. Polym. Sci. 2008, 33, 820–852. [Google Scholar] [CrossRef]
- Deroiné, M.; Le Duigou, A.; Corre, Y.M.; Le Gac, P.Y.; Davies, P.; César, G.; Bruzaud, S. Accelerated ageing of polylactide in aqueous environments: Comparative study between distilled water and seawater. Polym. Degrad. Stab. 2014, 108, 319–329. [Google Scholar] [CrossRef]
- Wang, Y.; Kong, Y.; Zhao, Y.; Feng, Q.; Wu, Y.; Tang, X.; Gu, X.; Yang, Y. Electrospun, reinforcing network-containing, silk fibroin-based nerve guidance conduits for peripheral nerve repair. J. Biomater. Tissue Eng. 2016, 6, 53–60. [Google Scholar] [CrossRef]
- Athanasiou, K.A.; Niederauer, G.G.; Agrawal, C.M. Sterilization, toxicity, biocompatibility and clinical applications of polylactic acid/polyglycolic acid copolymers. Biomaterials 1996, 17, 93–102. [Google Scholar] [CrossRef]
- Cheung, H.Y.; Lau, K.T. Study on a silkworm silk fiber/biodegradable polymer biocomposite. In Proceedings of the ICCM International Conferences on Composite Materials, Kyoto, Japan, 8–13 July 2007. [Google Scholar]
- Yeh, J.T.; Huang, C.Y.; Chai, W.L.; Chen, K.N. Plasticized properties of poly (lactic acid) and triacetine blends. J. Appl. Polym. Sci. 2009, 112, 2757–2763. [Google Scholar] [CrossRef]
- Burg, K.J.L.; Holder, W.D.; Culberson, C.R.; Beiler, R.J.; Greene, K.G.; Loebsack, A.B.; Roland, W.D.; Mooney, D.J.; Halberstadt, C.R. Parameters affecting cellular adhesion to polylactide films. J. Biomater. Sci. Polym. Ed. 1999, 10, 147–161. [Google Scholar] [CrossRef]
- Rasal, R.M.; Janorkar, A.V.; Hirt, D.E. Poly(lactic acid) modifications. Prog. Polym. Sci. 2010, 35, 338–356. [Google Scholar] [CrossRef]
- Paul, M.A.; Delcourt, C.; Alexandre, M.; Degée, P.; Monteverde, F.; Dubois, P. Polylactide/montmorillonite nanocomposites: Study of the hydrolytic degradation. Polym. Degrad. Stab. 2005, 87, 535–542. [Google Scholar] [CrossRef]
- Shogren, R.L.; Doane, W.M.; Garlotta, D.; Lawton, J.W.; Willett, J.L. Biodegradation of starch/polylactic acid/poly(hydroxyester-ether) composite bars in soil. Polym. Degrad. Stab. 2003, 79, 405–411. [Google Scholar] [CrossRef]
- Buzarovska, A.; Grozdanov, A. Biodegradable poly(L-lactic acid)/TiO2 nanocomposites: Thermal properties and degradation. J. Appl. Polym. Sci. 2012, 123, 2187–2193. [Google Scholar] [CrossRef]
- Yang, K.K.; Wang, X.L.; Wang, Y.Z. Progress in nanocomposite of biodegradable polymer. J. Ind. Eng. Chem. 2007, 13, 485–500. [Google Scholar]
- Huang, S.M.; Hwang, J.J.; Liu, H.J.; Lin, L.H. Crystallization behavior of poly(L-lactic acid)/montmorillonite nanocomposites. J. Appl. Polym. Sci. 2010, 117, 434–442. [Google Scholar] [CrossRef]
- Tang, H.; Chen, J.B.; Wang, Y.; Xu, J.Z.; Hsiao, B.S.; Zhong, G.J.; Li, Z.M. Shear flow and carbon nanotubes synergistically Induced nonisothermal crystallization of poly(lactic acid) and its application in injection molding. Biomacromolecules 2012, 13, 3858–3867. [Google Scholar] [CrossRef]
- Murariu, M.; Paint, Y.; Murariu, O.; Raquez, J.-M.; Bonnaud, L.; Dubois, P. Current progress in the production of PLA–ZnO nanocomposites: Beneficial effects of chain extender addition on key properties. J. Appl. Polym. Sci. 2015, 132, 42480. [Google Scholar] [CrossRef]
- Hakim, R.H.; Cailloux, J.; Santana, O.O.; Bou, J.; Sánchez-Soto, M.; Odent, J.; Raquez, J.M.; Dubois, P.; Carrasco, F.; Maspoch, M.L. PLA/SiO2 composites: Influence of the filler modifications on the morphology, crystallization behavior, and mechanical properties. J. Appl. Polym. Sci. 2017, 134, 45367. [Google Scholar] [CrossRef]
- Wu, G.; Liu, S.; Jia, H.; Dai, J. Preparation and properties of heat resistant polylactic acid (PLA)/Nano-SiO2 composite filament. J. Wuhan Univ. Technol. Mater. Sci. Ed. 2016, 31, 164–171. [Google Scholar] [CrossRef]
- Xiu, H.; Qi, X.; Bai, H.; Zhang, Q.; Fu, Q. Simultaneously improving toughness and UV-resistance of polylactide/titanium dioxide nanocomposites by adding poly(ether)urethane. Polym. Degrad. Stab. 2017, 143, 136–144. [Google Scholar] [CrossRef]
- Zapata, P.A.; Palza, H.; Cruz, L.S.; Lieberwirth, I.; Catalina, F.; Corrales, T.; Rabagliati, F.M. Polyethylene and poly(ethylene-co-1-octadecene) composites with TiO2 based nanoparticles by metallocenic “in situ” polymerization. Polymer 2013, 54, 2690–2698. [Google Scholar] [CrossRef]
- Fonseca, C.; Ochoa, A.; Ulloa, M.T.; Alvarez, E.; Canales, D.; Zapata, P.A. Poly(lactic acid)/TiO2 nanocomposites as alternative biocidal and antifungal materials. Mater. Sci. Eng. C 2015, 57, 314–320. [Google Scholar] [CrossRef]
- Wu, F.; Lan, X.; Ji, D.; Liu, Z.; Yang, W.; Yang, M. Grafting polymerization of polylactic acid on the surface of nano-SiO2 and properties of PLA/PLA-grafted-SiO2 nanocomposites. J. Appl. Polym. Sci. 2013, 129, 3019–3027. [Google Scholar] [CrossRef]
- Serenko, O.A.; Muzafarov, A.M. Polymer composites with surface modified SiO2 nanoparticles: Structures, properties, and promising applications. Polym. Sci. Ser. C 2016, 58, 93–101. [Google Scholar] [CrossRef]
- Ha, S.W.; Weitzmann, M.N.; Beck, G.R., Jr. Applications of silica-based nanomaterials in dental and skeletal biology. In Nanobiomaterials in Clinical Dentistry; Karthikeyan, W., Ahmed, J.K., Eds.; Elsevier: Amsterdam, The Netherlands, 2013; pp. 69–91. [Google Scholar]
- Galindo, I.R.; Viveros, T.; Chadwick, D. Synthesis and characterization of titania-based ternary and binary mixed oxides prepared by the sol−gel method and their activity in 2-propanol dehydration. Ind. Eng. Chem. Res. 2007, 46, 1138–1147. [Google Scholar] [CrossRef]
- Liau, S.Y.; Read, D.C.; Pugh, W.J.; Furr, J.; Russell, A.D. Interaction of silver nitrate with readily identifiable groups: Relationship to the antibacterialaction of silver ions. Lett. Appl. Microbiol. 1997, 25, 279–283. [Google Scholar] [CrossRef]
- Marra, A.; Silvestre, C.; Duraccio, D.; Cimmino, S. Polylactic acid/zinc oxide biocomposite films for food packaging application. Int. J. Biol. Macromol. 2016, 88, 254–262. [Google Scholar] [CrossRef]
- Sirelkhatim, A.; Mahmud, S.; Seeni, A.; Kaus, N.H.M.; Ann, L.C.; Bakhori, S.K.M.; Hasan, H.; Mohamad, D. Review on zinc oxide nanoparticles: Antibacterial activity and toxicity mechanism. Nano-Micro Lett. 2015, 7, 219–242. [Google Scholar] [CrossRef]
- Li, W.; Zhang, C.; Chi, H.; Li, L.; Lan, T.; Han, P.; Chen, H.; Qin, Y. Development of antimicrobial packaging film made from poly(lactic acid) incorporating titanium dioxide and silver nanoparticles. Molecules 2017, 22, 1170. [Google Scholar] [CrossRef]
- Shebi, A.; Lisa, S. Evaluation of biocompatibility and bactericidal activity of hierarchically porous PLA-TiO2 nanocomposite films fabricated by breath-figure method. Mater. Chem. Phys. 2019, 230, 308–318. [Google Scholar] [CrossRef]
- Swaroop, C.; Shukla, M. Polylactic acid/magnesium oxide nanocomposite films for food packaging applications. In Proceedings of the 21st International Conference on Composite Materials, Xi’an, China, 20–25 August 2017. [Google Scholar]
- Teamsinsungvon, A.; Sutapun, W.; Ruksakulpiwat, C.; Ruksakulpiwat, Y. Preparation of titanium-silica binary mixed oxide to use as a filler in poly (lactic acid). Suranaree J. Sci. Technol. 2019, 26, 31–36. [Google Scholar]
- Teamsinsungvon, A.; Ruksakulpiwat, C.; Amonpattaratkit, P.; Ruksakulpiwat, Y. Structural Characterization of Titanium–Silica Oxide Using Synchrotron Radiation X-ray Absorption Spectroscopy. Polymers 2022, 14, 2729. [Google Scholar] [CrossRef]
- Matijević, E.; Budnik, M.; Meites, L. Preparation and mechanism of formation of titanium dioxide hydrosols of narrow size distribution. J. Colloid Interface Sci. 1977, 61, 302–311. [Google Scholar] [CrossRef]
- Vorkapic, D.; Matsoukas, T. Effect of Temperature and Alcohols in the Preparation of Titania Nanoparticles from Alkoxides. J. Am. Ceram. Soc. 1998, 81, 2815–2820. [Google Scholar] [CrossRef]
- Cheung, H.Y.; Lau, K.T.; Tao, X.M.; Hui, D. A potential material for tissue engineering: Silkworm silk/PLA biocomposite. Compos. Part B Eng. 2008, 39, 1026–1033. [Google Scholar] [CrossRef]
- Boonying, S.; Sutapun, W.; Suppakarn, N.; Ruksakulpiwat, Y. Crystallization Behavior of Vetiver Grass Fiber-Polylactic Acid Composite. Adv. Mater. Res. 2012, 410, 55–58. [Google Scholar] [CrossRef]
- Tang, Z.; Zhang, C.; Liu, X.; Zhu, J. The crystallization behavior and mechanical properties of polylactic acid in the presence of a crystal nucleating agent. J. Appl. Polym. Sci. 2012, 125, 1108–1115. [Google Scholar] [CrossRef]
- Elsner, J.; Shefy-Peleg, A.; Zilberman, M. Novel biodegradable composite wound dressings with controlled release of antibiotics: Microstructure, mechanical and physical properties. J. Biomed. Mater. Res. Part B Appl. Biomater. 2010, 93, 425–435. [Google Scholar] [CrossRef]
- Teo, P.S.; Chow, W.S. Water vapour permeability of poly(lactic acid)/chitosan binary and ternary blends. Appl. Sci. Eng. Prog. 2014, 7, 23–27. [Google Scholar]
- Feng, S.; Zhang, F.; Ahmed, S.; Liu, Y. Physico-mechanical and antibacterial properties of PLA/TiO2 composite materials synthesized via electrospinning and solution casting processes. Coatings 2019, 9, 525. [Google Scholar] [CrossRef]
- Felfel, R.M.; Leander, P.; Miquel, G.F.; Tobias, M.; Gerhard, H.; Ifty, A.; Colin, S.; Virginie, S.; David, M.G.; Klaus, L. In vitro degradation and mechanical properties of PLA-PCL copolymer unit cell scaffolds generated by two-photon polymerization. Biomed. Mater. 2016, 11, 015011. [Google Scholar] [CrossRef]
- Racksanti, A.; Janhom, S.; Punyanitya, S.; Watanesk, R.; Watanesk, S. An approach for preparing an absorbable porous film of silk fibroin–rice starch modified with trisodium trimetaphosphate. J. Appl. Polym. Sci. 2015, 132, 41517. [Google Scholar] [CrossRef]
- Sarasua, J.R.; Prud’homme, R.E.; Wisniewski, M.; Le Borgne, A.; Spassky, N. Crystallization and melting behavior of polylactides. Macromolecules 1998, 31, 3895–3905. [Google Scholar] [CrossRef]
- Chen, P.; Zhou, H.; Liu, W.; Zhang, M.; Du, Z.; Wang, X. The synergistic effect of zinc oxide and phenylphosphonic acid zinc salt on the crystallization behavior of poly (lactic acid). Polym. Degrad. Stab. 2015, 122, 25–35. [Google Scholar] [CrossRef]
- Chen, R.Y.; Zou, W.; Wu, C.R.; Jia, S.K.; Huang, Z.; Zhang, G.Z.; Yang, Z.T.; Qu, J.P. Poly(lactic acid)/poly(butylene succinate)/calcium sulfate whiskers biodegradable blends prepared by vane extruder: Analysis of mechanical properties, morphology, and crystallization behavior. Polym. Test. 2014, 34, 1–9. [Google Scholar] [CrossRef]
- Zhang, H.; Huang, J.; Yang, L.; Chen, R.; Zou, W.; Lin, X.; Qu, J. Preparation, characterization and properties of PLA/TiO2 nanocomposites based on a novel vane extruder. RSC Adv. 2015, 5, 4639–4647. [Google Scholar] [CrossRef]
- Buzarovska, A. PLA nanocomposites with functionalized TiO2 nanoparticles. Polym. Plast. Technol. Eng. 2013, 52, 280–286. [Google Scholar] [CrossRef]
- Garlotta, D.; Doane, W.; Shogren, R.; Lawton, J.; Willett, J.L. Mechanical and thermal properties of starch-filled poly(D,L-lactic acid)/poly(hydroxy ester ether) biodegradable blends. J. Appl. Polym. Sci. 2003, 88, 1775–1786. [Google Scholar] [CrossRef]
- Yew, G.H.; Mohd Yusof, A.M.; Mohd Ishak, Z.A.; Ishiaku, U.S. Water absorption and enzymatic degradation of poly(lactic acid)/rice starch composites. Polym. Degrad. Stab. 2005, 90, 488–500. [Google Scholar] [CrossRef]
- Hu, Y.; Topolkaraev, V.; Hiltner, A.; Baer, E. Measurement of water vapor transmission rate in highly permeable films. J. Appl. Polym. Sci. 2001, 81, 1624–1633. [Google Scholar] [CrossRef]
- Choudalakis, G.; Gotsis, A.D. Permeability of polymer/clay nanocomposites: A review. Eur. Polym. J. 2009, 45, 967–984. [Google Scholar] [CrossRef]
- Tantekin-Ersolmaz, Ş.B.; Atalay-Oral, Ç.; Tatlıer, M.; Erdem-Şenatalar, A.; Schoeman, B.; Sterte, J. Effect of zeolite particle size on the performance of polymer–zeolite mixed matrix membranes. J. Membr. Sci. 2000, 175, 285–288. [Google Scholar] [CrossRef]
- Chen, L.; Zheng, K.; Liu, Y. Geopolymer-supported photocatalytic TiO2 film: Preparation and characterization. Constr. Build. Mater. 2017, 151, 63–70. [Google Scholar] [CrossRef]
- Zhuang, J.; Zhang, B.; Wang, Q.; Guan, S.; Li, B. Construction of novel ZnTiO3/g-C3N4 heterostructures with enhanced visible light photocatalytic activity for dye wastewater treatment. J. Mater. Sci. Mater. Electron. 2019, 30, 6322–6334. [Google Scholar] [CrossRef]
- Wang, Q.; Zhang, L.; Guo, Y.; Shen, M.; Wang, M.; Li, B.; Shi, J. Multifunctional 2D porous g-C3N4 nanosheets hybridized with 3D hierarchical TiO2 microflowers for selective dye adsorption, antibiotic degradation and CO2 reduction. Chem. Eng. J. 2020, 396, 125347. [Google Scholar] [CrossRef]
- Asmatulu, R.; Mahmud, G.A.; Hille, C.; Misak, H.E. Effects of UV degradation on surface hydrophobicity, crack, and thickness of MWCNT-based nanocomposite coatings. Prog. Org. Coat. 2011, 72, 553–561. [Google Scholar] [CrossRef]
- Oleyaei, S.A.; Zahedi, Y.; Ghanbarzadeh, B.; Moayedi, A.A. Modification of physicochemical and thermal properties of starch films by incorporation of TiO2 nanoparticles. Int. J. Biol. Macromol. 2016, 89, 256–264. [Google Scholar] [CrossRef] [PubMed]
- Cui, R.; Jiang, K.; Yuan, M.; Cao, J.; Li, L.; Tang, Z.; Qin, Y. Antimicrobial film based on polylactic acid and carbon nanotube for controlled cinnamaldehyde release. J. Mater. Res. Technol. 2020, 9, 10130–10138. [Google Scholar] [CrossRef]
- Chu, Z.; Zhao, T.; Li, L.; Fan, J.; Qin, Y. Characterization of Antimicrobial Poly (Lactic Acid)/Nano-Composite Films with Silver and Zinc Oxide Nanoparticles. Materials 2017, 10, 659. [Google Scholar] [CrossRef]
- Sinha Ray, S.; Yamada, K.; Okamoto, M.; Ueda, K. Polylactide-layered silicate nanocomposite: a novel biodegradable material. Nano Lett. 2002, 2, 1093–1096. [Google Scholar] [CrossRef]
- Luo, Y.B.; Wang, X.L.; Wang, Y.Z. Effect of TiO2 nanoparticles on the long-term hydrolytic degradation behavior of PLA. Polym. Degrad. Stab. 2012, 97, 721–728. [Google Scholar] [CrossRef]
- Kaseem, M.; Hamad, K.; Ur Rehman, Z. Review of recent advances in polylactic acid/TiO2 Composites. Materials 2019, 12, 3659. [Google Scholar] [CrossRef]
- Yuan, X.; Mak, A.F.T.; Yao, K. In vitro degradation of poly(L- lactic acid) fibers in phosphate buffered saline. J. Appl. Polym. Sci. 2002, 85, 936–943. [Google Scholar] [CrossRef]
- Fu, G.; Vary, P.S.; Lin, C.T. Anatase TiO2 nanocomposites for antimicrobial coatings. J. Phys. Chem. B 2005, 109, 8889–8898. [Google Scholar] [CrossRef]
- Joost, U.; Juganson, K.; Visnapuu, M.; Mortimer, M.; Kahru, A.; Nõmmiste, E.; Joost, U.; Kisand, V.; Ivask, A. Photocatalytic antibacterial activity of nano-TiO2 (anatase)-based thin films: Effects on Escherichia coli cells and fatty acids. J. Photochem. Photobiol. B Biol. 2015, 142, 178–185. [Google Scholar] [CrossRef]
- Jiang, X.; Lv, B.; Wang, Y.; Shen, Q.; Wang, X. Bactericidal mechanisms and effector targets of TiO2 and Ag-TiO2 against Staphylococcus aureus. J. Med. Microbiol. 2017, 66, 440–446. [Google Scholar] [CrossRef] [PubMed]
- Verdier, T.; Coutand, M.; Bertron, A.; Roques, C. Antibacterial Activity of TiO2 Photocatalyst Alone or in Coatings on E. coli: The Influence of Methodological Aspects. Coatings 2014, 4, 670–686. [Google Scholar] [CrossRef]
- Pleskova, S.N.; Golubeva, I.S.; Verevkin, Y.K. Bactericidal activity of titanium dioxide ultraviolet-induced films. Mater. Sci. Eng. C 2016, 59, 807–817. [Google Scholar] [CrossRef] [PubMed]
- Talebian, N.; Zare, E. Structure and antibacterial property of nano-SiO2 supported oxide ceramic. Ceram. Int. 2014, 40, 281–287. [Google Scholar] [CrossRef]

| Sample | Tensile Strength (MPa) | Elongation at Break (%) | Young’s Modulus (GPa) |
|---|---|---|---|
| PLA | 33.94 ± 1.38 | 19.62 ± 8.64 | 0.98 ± 0.23 |
| 97PLA/3TiO2 | 28.22 ± 1.47 | 18.1 ± 4.24 | 1.01 ± 0.04 |
| 97PLA/3SiO2 | 29.75 ± 1.38 | 11.8 ± 4.96 | 1.07 ± 0.10 |
| 97PLA/3Ti70Si30 | 35.64 ± 3.21 | 11.12 ± 1.81 | 1.18 ± 0.06 |
| 95PLA/5Ti70Si30 | 32.06 ± 2.29 | 9.88 ± 2.81 | 1.01 ± 0.10 |
| 97PLA/3Ti50Si50 | 35.31 ± 2.01 | 9.61 ± 2.57 | 1.29 ± 0.12 |
| 97PLA/3Ti40Si60 | 30.67 ± 1.74 | 22.30 ± 2.53 | 1.02 ± 0.05 |
| 97PLA/3TiO2SiO2 | 29.00 ± 1.42 | 58.37 ± 5.00 | 0.96 ± 0.07 |
| Samples | Tg, °C | Tcc, °C | ΔHc, J/g | Tm1, °C | Tm2, °C | ΔHm, J/g | Xc,% |
|---|---|---|---|---|---|---|---|
| PLA | 58.87 | 109.47 | 36.15 | 145.84 | 153.35 | 31.73 | 33.86 |
| 97PLA/3TiO2 | 56.86 | 107.36 | 33.61 | 144.89 | 152.72 | 33.17 | 36.50 |
| 97PLA/3SiO2 | 56.64 | 108.22 | 33.06 | 145.39 | 145.33 | 33.31 | 36.65 |
| 97PLA/3Ti70Si30 | 54.81 | 107.3 | 34.41 | 145.07 | 152.75 | 32.71 | 35.99 |
| 95PLA/5Ti70Si30 | 51.84 | 103.09 | 26.80 | 141.29 | 150.22 | 32.18 | 36.15 |
| 97PLA/3Ti50Si50 | 55.96 | 107.14 | 33.06 | 144.41 | 152.50 | 34.44 | 37.89 |
| 97PLA/3Ti40Si60 | 57.40 | 107.72 | 34.16 | 145.33 | 153.01 | 33.38 | 36.73 |
| 97PLA/3TiO2SiO2 | 57.46 | 107.79 | 30.54 | 145.39 | 153.07 | 32.31 | 35.55 |
| Samples | T0.05, °C | T0.5, °C | Td, °C | Tf, °C | Residual, % |
|---|---|---|---|---|---|
| PLA | 321.67 | 360.33 | 358.83 | 424.64 | 1.20 |
| 97PLA/3TiO2 | 336.17 | 363.67 | 363.17 | 429.22 | 4.07 |
| 97PLA/3SiO2 | 331.17 | 361.17 | 359.33 | 427.27 | 4.14 |
| 97PLA/3Ti70Si30 | 304.00 | 351.83 | 350.17 | 408.68 | 3.91 |
| 95PLA/5Ti70Si30 | 284.50 | 347.33 | 346.33 | 407.16 | 5.46 |
| 97PLA/3Ti50Si50 | 324.50 | 358.36 | 356.50 | 425.49 | 4.22 |
| 97PLA/3Ti40Si60 | 326.50 | 358.67 | 356.83 | 416.83 | 3.53 |
| 97PLA/3TiO2SiO2 | 330.67 | 362.33 | 361.33 | 418.69 | 4.50 |
| Sample | Transmittance, % | Opacity (AU.nm∙mm−1) | |||
|---|---|---|---|---|---|
| UV-C (240 nm) | UV-B (300 nm) | UV-A (360 nm) | Visible (600 nm) | ||
| PLA | 1.24 | 24.47 | 34.77 | 51.39 | 1.16 |
| 97PLA/3TiO2 | 0.00 | 0.12 | 0.41 | 1.98 | 6.81 |
| 97 PLA/3SiO2 | 0.04 | 9.48 | 18.03 | 38.37 | 2.31 |
| 97 PLA/3Ti70Si30 | 0.00 | 0.28 | 0.75 | 14.00 | 3.42 |
| 95 PLA/5Ti70Si30 | 0.00 | 0.00 | 0.36 | 4.06 | 6.33 |
| 97 PLA/3Ti50Si50 | 0.00 | 0.32 | 2.37 | 15.65 | 3.22 |
| 97 PLA/3Ti40Si60 | 0.00 | 0.03 | 0.81 | 10.48 | 3.92 |
| 97 PLA/3TiO2SiO2 | 0.00 | 0.19 | 1.43 | 7.30 | 4.74 |
| Time (Day) | Sample | Tensile Strength (MPa) | Elongation at Break (%) | Young’s Modulus (GPa) |
|---|---|---|---|---|
| 0 | PLA | 33.94 ± 1.38 | 19.62 ± 8.64 | 0.98 ± 0.23 |
| 97PLA/3TiO2 | 28.22 ± 1.47 | 18.1 ± 4.24 | 1.01 ± 0.04 | |
| 97PLA/3SiO2 | 29.75 ± 1.38 | 11.8 ± 4.96 | 1.07 ± 0.10 | |
| 97PLA/3Ti70Si30 | 35.64 ± 3.21 | 11.12 ± 1.81 | 1.18 ± 0.06 | |
| 95PLA/5Ti70Si30 | 32.06 ± 2.29 | 9.88 ± 2.81 | 1.01 ± 0.10 | |
| 97PLA/3Ti50Si50 | 35.31 ± 2.01 | 9.61 ± 2.57 | 1.29 ± 0.12 | |
| 97PLA/3Ti40Si60 | 30.67 ± 1.74 | 22.30 ± 2.53 | 1.02 ± 0.05 | |
| 97PLA/3TiO2SiO2 | 29.00 ± 1.42 | 58.37 ± 5.00 | 0.96 ± 0.07 | |
| 14 | PLA | 29.43 ± 3.02 | 3.81 ± 1.61 | 1.51 ± 0.14 |
| 97PLA/3TiO2 | 23.05 ± 2.87 | 2.58 ± 0.54 | 1.46 ± 0.31 | |
| 97PLA/3SiO2 | 23.53 ± 2.07 | 2.78 ± 0.27 | 1.39 ± 0.40 | |
| 97PLA/3Ti70Si30 | 33.56 ± 3.45 | 3.69 ± 0.61 | 1.74 ± 0.14 | |
| 95PLA/5Ti70Si30 | 31.75 ± 2.31 | 3.55 ± 0.70 | 1.49 ± 0.03 | |
| 97PLA/3Ti50Si50 | 30.75 ± 2.51 | 3.45 ± 0.80 | 1.29 ± 0.04 | |
| 97PLA/3Ti40Si60 | 27.99 ± 1.18 | 4.46 ± 0.95 | 1.21 ± 0.44 | |
| 97PLA/3TiO2SiO2 | 24.83 ± 2.35 | 3.25 ± 0.38 | 1.44 ± 0.56 | |
| 28 | PLA | 19.95 ± 2.45 | 2.06 ± 0.38 | 1.75 ± 0.25 |
| 97PLA/3TiO2 | 18.69 ± 2.02 | 1.98 ± 0.23 | 2.02 ± 0.00 | |
| 97PLA/3SiO2 | n/a * | n/a | n/a | |
| 97PLA/3Ti70Si30 | 29.35 ± 2.07 | 2.56 ± 0.12 | 1.91 ± 0.39 | |
| 95PLA/5Ti70Si30 | 10.03 ± 2.40 | 1.11 ± 0.33 | n/a | |
| 97PLA/3Ti50Si50 | 18.03 ± 2.80 | 2.11 ± 0.23 | n/a | |
| 97PLA/3Ti40Si60 | 17.56 ± 2.01 | 2.08 ± 0.13 | n/a | |
| 97PLA/3TiO2SiO2 | 17.39 ± 2.46 | 1.79 ± 0.35 | n/a | |
| 42 | PLA | 6.95 ± 2.49 | 1.33 ± 0.19 | n/a |
| 97PLA/3TiO2 | 0.26 ± 0.11 | 0.81 ± 0.10 | n/a | |
| 97PLA/3SiO2 | n/a | n/a | n/a | |
| 97PLA/3Ti70Si30 | 15.97 ± 2.62 | 1.52 ± 0.11 | n/a | |
| 95PLA/5Ti70Si30 | n/a | n/a | n/a | |
| 97PLA/3Ti50Si50 | 5.97 ± 2.63 | 0.62 ± 0.52 | n/a | |
| 97PLA/3Ti40Si60 | n/a | n/a | n/a | |
| 97PLA/3TiO2SiO2 | 3.24 ± 1.79 | 1.12 ± 0.64 | n/a |
| Samples | Blank (Ut) (t = 24 h) | Sample (At) (t = 24 h) | Antimicrobial Activity a (R) |
|---|---|---|---|
| Log CFU/mL | Log CFU/mL | ||
| PLA | 5.96 ± 0.01 | 5.87 ± 0.02 | 0.09 |
| 97PLA/3TiO2 | 5.96 ± 0.01 | 0.00 ± 0.00 | 5.96 |
| 97PLA/3Ti70Si30 | 5.96 ± 0.01 | 0.00 ± 0.00 | 5.96 |
| 95PLA/5Ti70Si30 | 5.96 ± 0.01 | 0.00 ± 0.00 | 5.96 |
| 97PLA/3Ti50Si50 | 5.96 ± 0.01 | 3.21 ± 0.04 | 2.75 |
| 97PLA/3TiO2SiO2 | 5.96 ± 0.01 | 2.53 ± 0.04 | 3.43 |
| Samples | Blank (Ut) (t = 24 h) | Sample (At) (t = 24 h) | Antimicrobial Activity a (R) |
|---|---|---|---|
| Log CFU/mL | Log CFU/mL | ||
| PLA | 4.35 ± 0.04 | 4.35 ± 0.04 | 0 |
| PLA/3TiO2 | 4.35 ± 0.04 | 0.00 ± 0.00 | 4.35 |
| PLA/3Ti70Si30 | 4.35 ± 0.04 | 2.96 ± 0.01 | 2.04 |
| PLA/5Ti70Si30 | 4.35 ± 0.04 | 0.00 ± 0.00 | 4.35 |
| PLA/3Ti50Si50 | 4.35 ± 0.04 | 3.17 ± 0.08 | 1.83 |
| PLA/3TiO2SiO2 | 4.35 ± 0.04 | 3.21 ± 0.01 | 1.79 |
Publisher’s Note: MDPI stays neutral with regard to jurisdictional claims in published maps and institutional affiliations. |
© 2022 by the authors. Licensee MDPI, Basel, Switzerland. This article is an open access article distributed under the terms and conditions of the Creative Commons Attribution (CC BY) license (https://creativecommons.org/licenses/by/4.0/).
Share and Cite
Teamsinsungvon, A.; Ruksakulpiwat, C.; Ruksakulpiwat, Y. Effects of Titanium–Silica Oxide on Degradation Behavior and Antimicrobial Activity of Poly (Lactic Acid) Composites. Polymers 2022, 14, 3310. https://doi.org/10.3390/polym14163310
Teamsinsungvon A, Ruksakulpiwat C, Ruksakulpiwat Y. Effects of Titanium–Silica Oxide on Degradation Behavior and Antimicrobial Activity of Poly (Lactic Acid) Composites. Polymers. 2022; 14(16):3310. https://doi.org/10.3390/polym14163310
Chicago/Turabian StyleTeamsinsungvon, Arpaporn, Chaiwat Ruksakulpiwat, and Yupaporn Ruksakulpiwat. 2022. "Effects of Titanium–Silica Oxide on Degradation Behavior and Antimicrobial Activity of Poly (Lactic Acid) Composites" Polymers 14, no. 16: 3310. https://doi.org/10.3390/polym14163310
APA StyleTeamsinsungvon, A., Ruksakulpiwat, C., & Ruksakulpiwat, Y. (2022). Effects of Titanium–Silica Oxide on Degradation Behavior and Antimicrobial Activity of Poly (Lactic Acid) Composites. Polymers, 14(16), 3310. https://doi.org/10.3390/polym14163310

